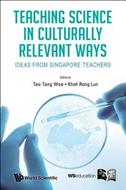

L’articolo è stato aggiunto alla lista dei desideri
IBS.it, l'altro eCommerce
Teaching Science In Culturally Relevant Ways: Ideas From Singapore Teachers
Cliccando su “Conferma” dichiari che il contenuto da te inserito è conforme alle Condizioni Generali d’Uso del Sito ed alle Linee Guida sui Contenuti Vietati. Puoi rileggere e modificare e successivamente confermare il tuo contenuto. Tra poche ore lo troverai online (in caso contrario verifica la conformità del contenuto alle policy del Sito).
Grazie per la tua recensione!
Tra poche ore la vedrai online (in caso contrario verifica la conformità del testo alle nostre linee guida). Dopo la pubblicazione per te +4 punti
Altre offerte vendute e spedite dai nostri venditori

Tutti i formati ed edizioni
Promo attive (1)
This book encapsulates the vision of Singapore science educators to bring the local elements of the country to bear in the science curriculum. In experimenting with familiar materials used and consumed in our everyday lives, and applying scientific knowledge to analyse and provide explanations of the observed phenomena the editors and contributing authors hope to introduce culturally relevant science activities for enactment in the formal and informal science curriculum. This work is premised on the collective belief that learning science in culturally relevant ways underscores the importance of one's culture embodied with funds of knowledge to make the learning of science meaningful. They see this as a step toward achieving the broader and long-term goal of developing a scientifically literate citizenry.
L'articolo è stato aggiunto al carrello
Le schede prodotto sono aggiornate in conformità al Regolamento UE 988/2023. Laddove ci fossero taluni dati non disponibili per ragioni indipendenti da IBS, vi informiamo che stiamo compiendo ogni ragionevole sforzo per inserirli. Vi invitiamo a controllare periodicamente il sito www.ibs.it per eventuali novità e aggiornamenti.
Per le vendite di prodotti da terze parti, ciascun venditore si assume la piena e diretta responsabilità per la commercializzazione del prodotto e per la sua conformità al Regolamento UE 988/2023, nonché alle normative nazionali ed europee vigenti.
Per informazioni sulla sicurezza dei prodotti, contattare productsafetyibs@feltrinelli.it
L’articolo è stato aggiunto alla lista dei desideri

